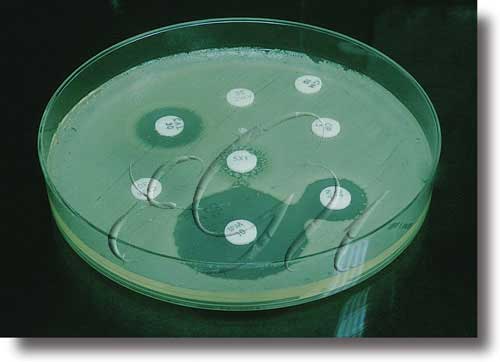

antibiograma
antibiograma
(< antibio(tico)
-
s
m
[MICROB]
Determinación da sensibilidade aos antibióticos, que se aplica no estudo das bacterias e, ás veces, dos fungos. As técnicas máis empregadas baséanse en sementar sobre un medio sólido o microorganismo a estudiar; incorpóraselle o antibiótico, que impregna un pequeno disco de papel e, posteriormente, mídese a súa proliferación en torno ao disco de papel.
-
s
m
[MICROB]
Sensibilidade dos fungos, bacterias, etc, á acción dalgúns quimioterapéuticos (sulfamidas, nitrofurantoína, etc).